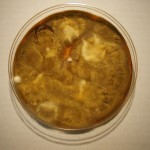
Black Mold: Chaetomium

Chaetomium: The Other Black Mold
-
Aspergillus niger
-
Chaetomium
-
Nigrospora
-
Stachybotrys
-
Auerobasidium
-
Alternaria
As expected Black Mold Symptoms vary for each mold type. For this blog post we are limiting our discussion to Chaetomium . Chaetomium is a demataceous mold, meaning its spore is darkly pigmented, with roughly 80 known reported species.
One species is Chaetomium globosum, and is frequently found in water damaged builings. Thriving under the same environmental conditions that Stachybotrys does, both types are routinely discovered growing in the same location.
Now on to the health effects. OSHA lists 4 species of Chaetomium in their 1994 report (3) under the heading:
TOXIC SUBSTANCES CONTROL ACT (TSCA) CHEMICAL SUBSTANCE INVENTORY, 1985 EDITION VOLUME V: UVCB INDEX
Another source, “the website (www.mold-help.org) describes C.globosum as allergenic and an agent of onychomycoses (nasal infection), peritonitis, cutaneous lesions and potential agent in fatal systemic mycoses. It is also says “No toxic diseases have been documented to date”(1)
We also came across recent research study Isolation, purification and characterization of proteins from indoor strains of Chaetomium globosum that are antigenic to humans by Provost, Natacha B., M.Sc 2010 the abstract reads:
“Chaetomium globosum grows on damp cellulosic materials indoors and can adversely affect human health through allergic and toxic reactions. To study allergic response, exposure assessments must be done by measuring human allergens or antigens. The goal of this research was to identify C. globosum proteins that are antigenic to humans” (4). to read complete paper or order a copy please see resource link (4) below.
Black Mold such as Chaetomium is easily identified by a direct examination under the microscope.
Another related blog post you might be interested in is: Aspergillus niger and Garlic
Helpful resources:
